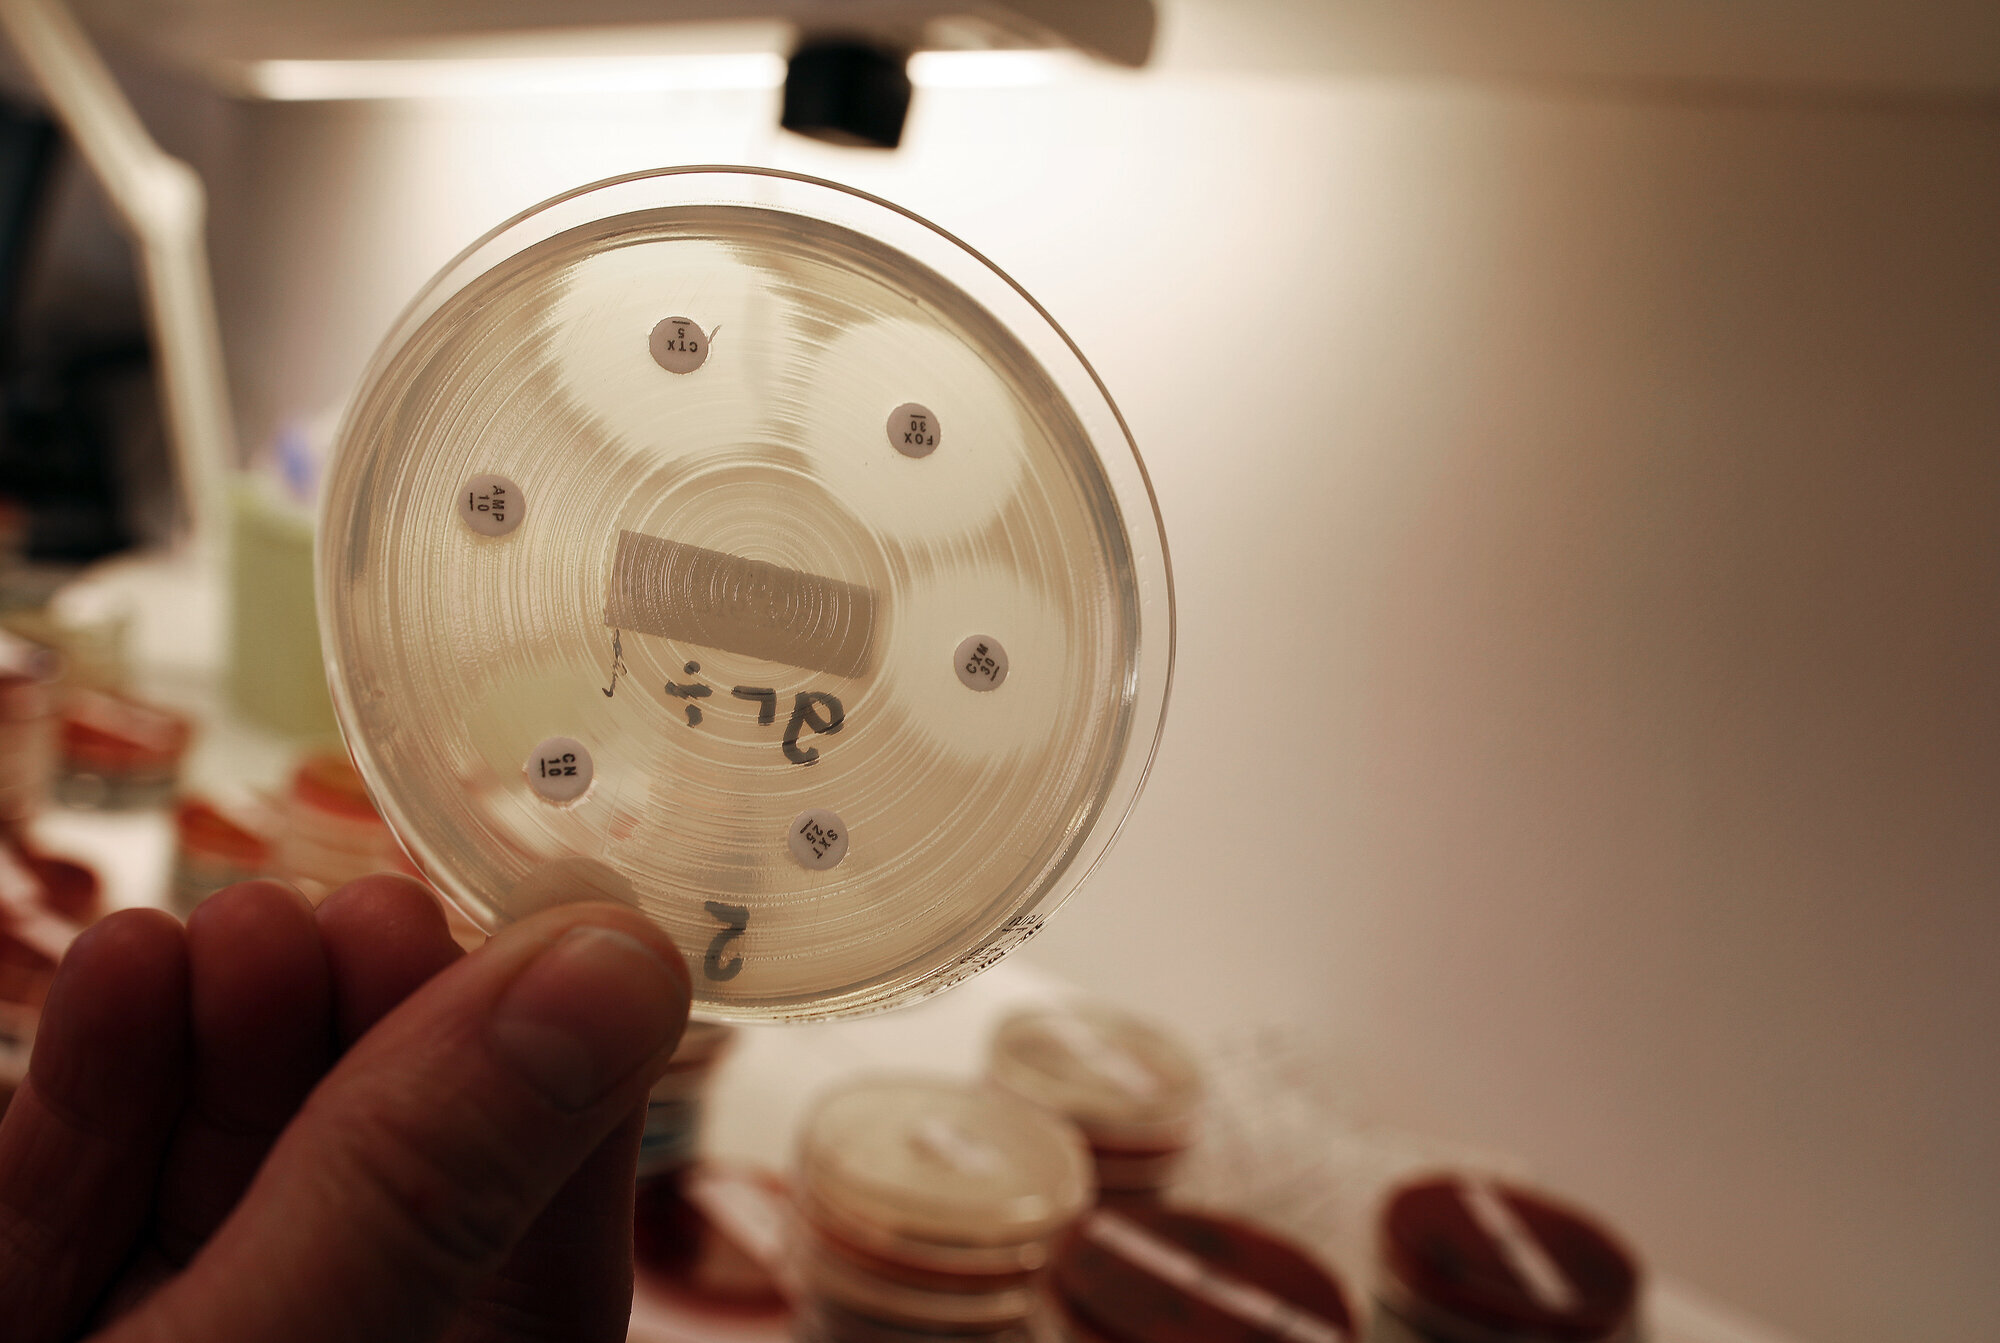

Klebsiella-jakten i Tromsø

Ved UNN i Tromsø har de i over to år jobbet hardt for å finne smittekilden til en multiresistent Klebsiella-bakterie.
I august 2013 ringte telefonen ved Smittevernsenteret på Universitetssykehuset i Tromsø (UNN).
I andre enden var mikrobiologisk laboratorium, en annen avdeling ved sykehuset. De hadde analysert noen prøver, og reagerte på utslagene.
En av bakteriestammene så ut til å være uvanlig resistent.
Klebsiella pneumonia er en bakterie som er vanlig å finne i tarmen hos mennesker.
Det spesielle i disse prøvene, var at klebsiella-stammen hadde ervervet resistens mot de aller fleste typer antibiotika.
Den hadde resistensmekanismen ESBL, som betyr at den kan bryte ned betalaktamantibiotika.
I tillegg hadde den resistensmekanismer mot flere andre antibiotikaklasser.
– Til denne bakterien hadde vi bare et middel igjen. Og dersom vi bruker dette middelet i for stor grad, kan det være et tidsspørsmål før også det slutter å virke. Det er ikke noen hyggelig situasjon å være i.
Det sier Torni Myrbakk (bildet), smittevernoverlege ved avdeling for mikrobiologi og smittevern ved sykehuset. Både leger og sykepleiere jobber i avdelingen.
Myrbakk understreker at multiresistente bakterier ikke er et særskilt problem for UNN, men noe helsevesenet over hele verden må forholde seg til.

Etter telefonen fra mikrobiologen ble det umiddelbart satt i gang tiltak. De kliniske prøvene viste at to pasienter ved sykehuset var bærere av den ESBL-holdige bakterien Klebsiella.
Pasientene fikk enerom, og pasientforløpene til de to som var smittet ble gjennomgått.
– Ansatte ble minnet om å følge basale smittevernrutiner. Det ble tatt prøver av medpasienter for å se om det var flere som var smittet.
Men de fant ikke noen felles smittekilde.
Månedene gikk, og det dukket stadig opp flere pasienter med funn av den samme bakterien. Detektivarbeidet ble mer omfattende:
– Pasientene hadde tilknytning til forskjellige avdelinger, og det var ingen tydelig link mellom dem.
De snakket med avdelingene, gikk gjennom pasientjournalene. Hvilke undersøkelser var blitt utført, hvilket rom hadde pasienten ligget på, hvilken hjemkommune kom de fra, hvilket sykehjem hadde de bodd på? Typer operasjon, var det utført skopiundersøkelser, innleggelseshistorikken til alle ble kartlagt tilbake til januar 2012.
Alt dette gjorde de på alle tilfellene som kom inn, til sammen 69 pasienter.
– Vi så også på antibiotikabruken.
Men en felles smittekilde ble fremdeles ikke funnet.

– Hvis man ser på tilsvarende utbrudd i land utenfor Norge, er det ikke uvanlig å konkludere med at man ikke finner en enkelt kilde, men at helsepersonell kan være en viktig faktor i smittespredningen.
– Altfor ofte skjer det brudd i basale smittevernrutiner, som for eksempel håndhygiene, sier Myrbakk.
Den foreløpige utbruddstoppen var høsten 2014. Da ble informasjon om utbruddet og om ESBL-holdige bakterier generelt og hvordan forebygge smitte intensivert ut til avdelingene.
Fellesnevneren for pasientene var at de hadde høy alder, hadde vært mye inn og ut av sykehus, og at de hadde fått mye antibiotika.
– Det er en utfordrende situasjon, for vi vet ikke når pasienten ble smittet. Man kan være bærer lenge før bakterien dukker opp i kliniske prøver. Dette er heller ikke en type bakterie som er meldepliktig, sier hun, og sender en takk for årvåkenheten fra laboratoriet sin side. Sykehuset har hatt løpende kontakt med andre sykehus og Folkehelseinstituttet for å diskutere situasjonen.
– Problemet med et slikt utbrudd er at det kan være ulmende i starten. Er det et utbrudd eller er det forventet utvikling med tanke på at disse bakteriene er økende i samfunnet generelt?

Situasjonen per nå, er at det kommer et og annet tilfelle, men langt sjeldnere enn i 2014.
De tre viktigste tiltakene sykehuset har landet på er:
* Fokus på basale smittevernrutiner
* Reduksjon av bredspekret antibiotika
* Forsterkede smitteverntiltak rundt pasienter som tilhører utbruddet.
Klebsiella-utbruddet har gitt lærdom:
– Det er viktig å være systematisk helt fra starten. Vi vet nå mer om hva vi spesifikt skal se etter som risikofaktorer, og vi er mer oppmerksomme på hvor viktig det er med god informasjon til ansatte og ledere tidlig.
Men om denne bakterien noen sinne vil forsvinne helt ut fra sykehuset, er høyst usikkert.
– Håndtering av multiresistente bakterier vil nok dessverre bli mer og mer en normaltilstand ved norske sykehus, slik det allerede er mange andre steder i verden, sier hun.
Kreftavdelingen, sengepost, UNN:

At resistente bakterier har blitt vanligere, kan Bente Lis Roaldsen, leder for sykepleierne på Kreftavdelingen ved UNN skrive under på.
– Økning i pasienter med ESBL er markant.
På avdelingen er det svært syke pasienter, mange med nedsatt immunforsvar. De skal ikke bli smittet av andre. Men hva når disse pasientene selv blir bærere av en multiresistent bakterie?
– Jeg er ikke i tvil om at det er en stor ekstrabelastning. Pasienten er innlagt med en potensielt dødelig sykdom. I tillegg må man kanskje isoleres fordi man utgjør en fare for andre. Det er en stor psykisk påkjenning. Vi har pasienter med små barn, og pasienten vil selvsagt være mest mulig sammen med barna og gjøre mest mulig normale og hyggelige ting. Fullt smittevernutstyr og fareskilt på døra gjør ikke situasjonen enklere for verken pasienter eller pårørende.
– Sykepleiere, leger og annet helsepersonell er de som kan overføre denne smitten om vi ikke er svært nøye med å følge retningslinjene for basale smittevernrutiner, sier Roaldsen.
Folkehelseinstituttet har kommet med nye retningslinjer for å hindre spredning og etablering av ESBL-holdige bakterier i norske helseinstitusjoner. I retningslinjene frarådes blant annet at pasienter med ESBL benytter seg av åpen buffé. Bente Lis Roaldsen bekrefter at det har hersket uenighet rundt om buffé er ok eller ikke.
Smittevernsenteret på UNN ønsker ikke at det skal være åpen buffé på sykehuset.
– Det med buffé er et vanskelig spørsmål. Jeg ser helt klart smittevernsgrunner til at vi ikke skal ha den. Samtidig har buffeen en sosial funksjon, og gir pasientene mer fleksibilitet rundt hva de ønsker å spise når, sier hun.
Det er også andre fysiske hindre for optimalt smittevern på avdelingen:
– Det er en rommessig utfordring. Vi har rett og slett ikke rom nok til å isolere både de som trenger beskyttende isolat og kontaktisolat. Det er mangel på enerom som i seg selv er et godt smitteverntiltak for å unngå kryss-smitte.
Arbeidsmessig og ressursmessig er det også en ekstrabelastning for personalet:
– Fordi vi ikke har sluser, må vi legge til rette ute på gangen, og må ha en som kan gå til hånde på utsiden av rommet, så det krever en helt annen planlegging.
– For å unngå spredning, må smittevern alltid være i fokus, og basale smittevernrutiner må følges, uavhengig av om det er kjent smitte, understreker Roaldsen.
– Som ledere har vi et stort ansvar for forebygging gjennom kunnskapsbygging og oppfølging av smittevernrutiner. Blant annet skal lederne gjennomføre månedlige smittevernvisitter i de kliniske avdelingene ved UNN, forteller Roaldsen.
– Det tror jeg bidrar til en bevisstgjøring av alle som jobber ved sykehuset.










































0 Kommentarer